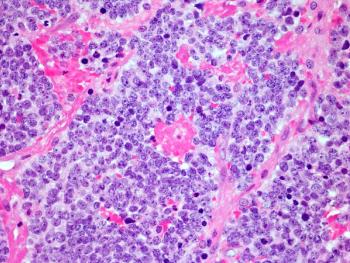

The authors believe the results may serve as a foundation for hepatitis D virus (HDV) testing among hepatitis B virus surface antigen (HBsAg)-positive specimens.

The authors believe the results may serve as a foundation for hepatitis D virus (HDV) testing among hepatitis B virus surface antigen (HBsAg)-positive specimens.

The approval expands the therapy’s indication to children as young as 7 years.

A study reveals sasanlimab enhances event-free survival in high-risk bladder cancer patients, offering new hope against disease recurrence.

Pharmacists should continue to emphasize the vaccine’s effectiveness in preventing cancer and be prepared to address patient safety concerns.

COVID-19 can reshape one’s academic journey and outlook on life.

The Lumipulse G pTau217/ß-Amyloid 1-42 Plasma Ratio is the first in vitro diagnostic device that tests blood to aid in diagnosing Alzheimer disease.

The vaccine, indicated with a restriction on use for those younger than 65 years and without comorbidities, was proven safe and effective in a series of large clinical trials, and marks the first protein-based vaccine to be approved in the United States.

Patients should understand that routine skin care is an important facet in the overall management of diabetes.
Naxitamab-gqgk has been added as a Category 2A recommendation in the updated National Comprehensive Cancer Network (NCCN) guidelines for high-risk neuroblastoma, reflecting growing consensus on its role in treating relapsed or refractory disease.

Cynthia Ryan, PharmD, BCPS, discusses practical, evidence-based strategies for pharmacists to identify, prevent, and manage dermatologic toxicities associated with cancer therapies, emphasizing interdisciplinary collaboration, patient education, and proactive supportive care to improve adherence and outcomes.

Aficamten, a cardiac myosin inhibitor, gains FDA approval, offering hope for improved cardiovascular health in patients with obstructive hypertrophic cardiomyopathy.

Implementation of a guidance document for periprocedural antibiotic prophylaxis resulted in improved appropriateness of antibiotic dose, selection, and duration for interventional radiology procedures.

New data reveals that combining pertuzumab with trastuzumab significantly improves survival rates in HER2+ breast cancer patients, reducing death risk by 17%.

Advocacy fosters professional development, creates better working conditions, and enhances patient care.

The new guidelines urge health care professionals to offer local anesthetics and other medications for intrauterine device (IUD) insertions and other gynecologic procedures.

The regimen, which consists of durvalumab and Bacillus Calmette-Guerin, offers new hope to patients with high-risk non-muscle-invasive bladder cancer.

Omalizumab expands its role in allergy management, now FDA-approved for food allergies, showcasing potential for broader applications in allergic rhinitis.

A new study reveals that heart failure patients with implantable devices are more likely to receive the pneumococcal conjugate vaccine 13, impacting vaccination rates and mortality.

Specialty pharmacists enhance CKD management through personalized care, medication adherence strategies, and collaboration with health care providers.

These pharmacists help bridge gaps for patients in difficult situations.

The FDA approves retifanlimab for advanced anal cancer, offering new hope with improved survival rates and treatment options for patients.


Combining olaparib with neoadjuvant chemotherapy enhances survival rates for early-stage gBRCAm triple-negative breast cancer, offering new hope for patients.

Ibrutinib offers comparable survival outcomes for high-risk chronic lymphocytic leukemia patients, challenging traditional prognostic markers in real-world settings.

Pharmacy staff can be instrumental members of shortage management teams.

In patients with synchronous metastatic colorectal cancer treated without curative intent, high low-density lipoprotein (LDL) cholesterol was associated with poor survival.

Cure Rare Disease's CRD-002 receives FDA orphan drug designation, advancing hope for SCA3 treatment with innovative oligonucleotide therapy.

With Oregon, Colorado, and New Mexico legalizing psilocybin-assisted therapy, opportunities for treatment are expanding.

The approved injection contains dihydroergotamine (DHE), which is the same medication used in hospitals, in a ready-to-use device.

Explore the latest advancements in RSV vaccination strategies for newborns, focusing on maternal immunization and post-birth protection options.